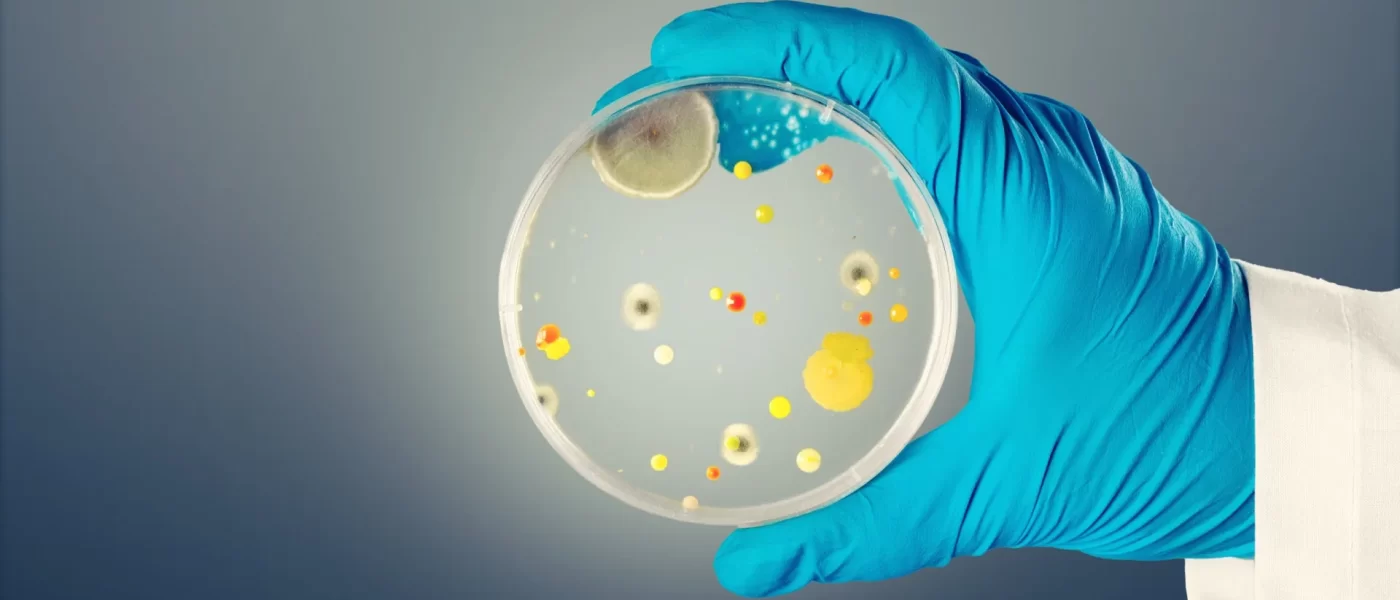

Vírus mortal Candida auris se espalha pela Europa e acende alerta global
[[{“value”:”
Candida auris é um fungo mortal que tem preocupado autoridades de saúde em todo o mundo. Ele se espalha rapidamente em hospitais e já foi identific…
leia mais no Notícias ao Minuto Brasil aqui.
“}]]